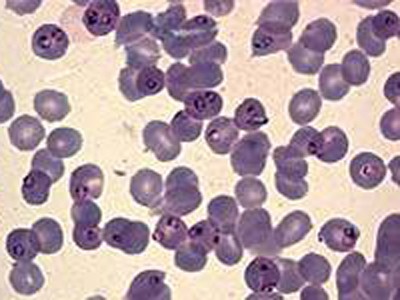
Мазок крови при малярии

Другие названия и синонимы
B54 Unspecified malaria, B54.
Описание
Малярия - паразитарная инфекция, приводящая к разрушению эритроцитов, которую переносят москиты. Фактор риска - поездки в регионы или проживание в областях, где наблюдаются вспышки малярии. Возраст, пол, генетика значения не имеют.
Более чем треть людей в мире больны малярией. В тропических странах каждый год заболевают 10 миллионов человек, а погибают от малярии 2 миллиона. Малярия является самой серьезной угрозой жизни для людей, которые выезжают в тропические страны.
Уже много лет Всемирная организация здравоохранения пытается контролировать малярию, но удается достигнуть лишь временного успеха. Малярийные паразиты передаются людям комарами рода анофелес, которые приобрели устойчивость к любым инсектицидам. В большинстве регионов мира и сами возбудители малярии приобрели устойчивость к распространенным противомалярийным лекарствам. До сих пор не разработано ни одной эффективной вакцины, которая защищала бы человека от этой инфекции.
Если пациент живет в регионе, где распространена малярия, то вполне возможно он уже перенес несколько легких приступов болезни, что повысило сопротивляемость его организма и снизило риск развития тяжелой формы. Но эта защита сохранится лишь в течение года при переезде в свободные от малярии регионы. Следовательно, если человек уехал из малярийных регионов, а затем вернулся, то ему придется принять профилактические меры. Если он заболел после поездки в тропики, обязательно следует сказать врачу, где он был и когда вернулся.
Симптомы.
Характерные симптомы малярии известны вот уже 2000 лет, но причину болезни нашли только в 1880 году. У людей малярию вызывают четыре вида простейших из рода плазмодиев, причем каждый вид вызывает свою форму малярии. Самой опасной формой считается молниеносная трехдневная малярия, возбудитель которой - Plasmodium falciparum. Эта форма малярии характеризуется очень высокой смертностью, и больной, оставшийся без лечения, часто умирает через 48 часов после появления первых симптомов. Три остальные формы малярии, вызываемые Plasmodium malariae, Plasmodium ovale и Plasmodium vivax, не столь тяжелы.
Все виды малярийных паразитов передаются человеку через укусы комаров. Вначале плазмодии размножаются в печени, а затем попадают в кровь, где проникают в эритроциты. Через 48-72 часа инфицированные клетки лопаются, и плазмодии проникают в другие эритроциты. Если неинфицированный москит укусит больного человека, то насекомое станет переносчиком и затем передаст инфекцию другим людям.
Симптомы малярии обычно появляются в период от 10 дней до 6 недель после укуса зараженным комаром. В некоторых случаях болезнь никак не дает о себе знать в течение месяцев и даже лет, особенно если во время заражения человек принимал противомалярийные лекарства для профилактики.
При отсутствии лечения заражение P. malariae, P. ovale и P. vivax сопровождается рецидивирующими приступами болезни, во время которых малярийные плазмодии выходят из инфицированных эритроцитов, разрушая их. Каждый приступ продолжается примерно 4-8 часов с интервалами 2 или 3 дня в зависимости от вида плазмодиев. Во время приступов наблюдаются следующие симптомы:
• высокая температура;
• озноб и дрожь;
• сильная потливость;
• спутанность сознания;
• слабость, головные и мышечные боли.
Между приступами основным симптомом болезни является сильная слабость. Молниеносная трехдневная малярия сопровождается высокой температурой, которую можно спутать с проявлением гриппа . Это самая тяжелая форма, ее приступы приводят к потери сознания и почечной недостаточности. Эта форма малярии опасна для жизни.
Врач может предположить, что у больного началась малярия, если в течение года после поездки в тропики, где распространена малярия, наблюдались эпизоды необъяснимого повышения температуры.
Диагностика.
Диагноз подтверждается выявлением малярийного плазмодия при исследовании мазков крови под микроскопом. Если у вас диагностировали малярию, нужно как можно раньше начать прием противомалярийных препаратов, чтобы избежать осложнений.
Лечение.
Лечение зависит от формы малярии, сопротивляемости паразитов лекарствам и тяжести симптомов. Если у больного молниеносная трехдневная малярия, то требуется лечение в стационаре пероральными или внутривенными противомалярийными лекарствами. Для лечения используют также переливание крови (для замещения разрушенных эритроцитов) или почечный диализ (при нарушении работы почек). Другие формы малярии обычно лечат амбулаторно, назначая курс противомалярийных лекарств. При своевременном лечении прогноз обычно благоприятный, и большинство больных полностью выздоравливает. Но малярия, вызванная P. ovale и P. vivax, часто дает рецидивы после лечения.
Профилактика малярии.
Если человек планирует посетить страны, где распространена малярия, необходимо расспросить врача о новейших противомалярийных лекарствах . Путешественнику следует начать прием противомалярийных препаратов за несколько дней до отъезда и продолжать его после возвращения домой. Для защиты от укусов москитов необходимо:
Тщательно закрывать свое тело;
Спать только под противомоскитной сеткой, которая пропитана соответствующим репеллентом;
Использовать репелленты для одежды и открытых участков кожи.
Эти меры особенно необходимы в период от заката до рассвета, когда москиты-переносчики инфекции - особенно активны.
Более чем треть людей в мире больны малярией. В тропических странах каждый год заболевают 10 миллионов человек, а погибают от малярии 2 миллиона. Малярия является самой серьезной угрозой жизни для людей, которые выезжают в тропические страны.
Уже много лет Всемирная организация здравоохранения пытается контролировать малярию, но удается достигнуть лишь временного успеха. Малярийные паразиты передаются людям комарами рода анофелес, которые приобрели устойчивость к любым инсектицидам. В большинстве регионов мира и сами возбудители малярии приобрели устойчивость к распространенным противомалярийным лекарствам. До сих пор не разработано ни одной эффективной вакцины, которая защищала бы человека от этой инфекции.
Если пациент живет в регионе, где распространена малярия, то вполне возможно он уже перенес несколько легких приступов болезни, что повысило сопротивляемость его организма и снизило риск развития тяжелой формы. Но эта защита сохранится лишь в течение года при переезде в свободные от малярии регионы. Следовательно, если человек уехал из малярийных регионов, а затем вернулся, то ему придется принять профилактические меры. Если он заболел после поездки в тропики, обязательно следует сказать врачу, где он был и когда вернулся.
Симптомы.
Характерные симптомы малярии известны вот уже 2000 лет, но причину болезни нашли только в 1880 году. У людей малярию вызывают четыре вида простейших из рода плазмодиев, причем каждый вид вызывает свою форму малярии. Самой опасной формой считается молниеносная трехдневная малярия, возбудитель которой - Plasmodium falciparum. Эта форма малярии характеризуется очень высокой смертностью, и больной, оставшийся без лечения, часто умирает через 48 часов после появления первых симптомов. Три остальные формы малярии, вызываемые Plasmodium malariae, Plasmodium ovale и Plasmodium vivax, не столь тяжелы.
Все виды малярийных паразитов передаются человеку через укусы комаров. Вначале плазмодии размножаются в печени, а затем попадают в кровь, где проникают в эритроциты. Через 48-72 часа инфицированные клетки лопаются, и плазмодии проникают в другие эритроциты. Если неинфицированный москит укусит больного человека, то насекомое станет переносчиком и затем передаст инфекцию другим людям.
Симптомы малярии обычно появляются в период от 10 дней до 6 недель после укуса зараженным комаром. В некоторых случаях болезнь никак не дает о себе знать в течение месяцев и даже лет, особенно если во время заражения человек принимал противомалярийные лекарства для профилактики.
При отсутствии лечения заражение P. malariae, P. ovale и P. vivax сопровождается рецидивирующими приступами болезни, во время которых малярийные плазмодии выходят из инфицированных эритроцитов, разрушая их. Каждый приступ продолжается примерно 4-8 часов с интервалами 2 или 3 дня в зависимости от вида плазмодиев. Во время приступов наблюдаются следующие симптомы:
• высокая температура;
• озноб и дрожь;
• сильная потливость;
• спутанность сознания;
• слабость, головные и мышечные боли.
Между приступами основным симптомом болезни является сильная слабость. Молниеносная трехдневная малярия сопровождается высокой температурой, которую можно спутать с проявлением гриппа . Это самая тяжелая форма, ее приступы приводят к потери сознания и почечной недостаточности. Эта форма малярии опасна для жизни.
Врач может предположить, что у больного началась малярия, если в течение года после поездки в тропики, где распространена малярия, наблюдались эпизоды необъяснимого повышения температуры.
Диагностика.
Диагноз подтверждается выявлением малярийного плазмодия при исследовании мазков крови под микроскопом. Если у вас диагностировали малярию, нужно как можно раньше начать прием противомалярийных препаратов, чтобы избежать осложнений.
Лечение.
Лечение зависит от формы малярии, сопротивляемости паразитов лекарствам и тяжести симптомов. Если у больного молниеносная трехдневная малярия, то требуется лечение в стационаре пероральными или внутривенными противомалярийными лекарствами. Для лечения используют также переливание крови (для замещения разрушенных эритроцитов) или почечный диализ (при нарушении работы почек). Другие формы малярии обычно лечат амбулаторно, назначая курс противомалярийных лекарств. При своевременном лечении прогноз обычно благоприятный, и большинство больных полностью выздоравливает. Но малярия, вызванная P. ovale и P. vivax, часто дает рецидивы после лечения.
Профилактика малярии.
Если человек планирует посетить страны, где распространена малярия, необходимо расспросить врача о новейших противомалярийных лекарствах . Путешественнику следует начать прием противомалярийных препаратов за несколько дней до отъезда и продолжать его после возвращения домой. Для защиты от укусов москитов необходимо:
Тщательно закрывать свое тело;
Спать только под противомоскитной сеткой, которая пропитана соответствующим репеллентом;
Использовать репелленты для одежды и открытых участков кожи.
Эти меры особенно необходимы в период от заката до рассвета, когда москиты-переносчики инфекции - особенно активны.
|
|
Связанные заболевания
|